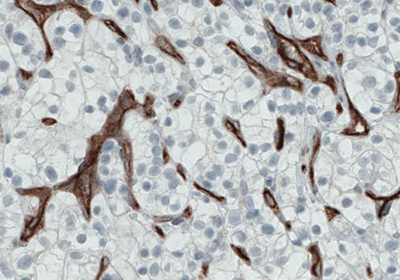
Immunohistochemical staining of Endoglin/CD105

Mesenchymal Stem Cell Markers and Antibodies
- Mesenchymal Stem Cell Markers
- Fibroblasts and Connective Tissue Cells
- Chondrocytes and Cartilage Cells
- Adipocytes and White Fat Tissue Cells
- Osteoblasts and Bone Cells
- Smooth, Cardiac, and Skeletal Muscle Cells
- Available Mesenchymal Stem Cell Markers and Antibodies
Mesenchymal Stem Cell Markers
In general, stem cells are specialized cells capable of self-renewal through cell division with the capability to differentiate into multi-lineage cells. Mesenchymal stem cells (MSCs) are tissue stem cells. They are ‘multipotent’, implying that they can differentiate into more than one cell type in the body.

Figure 1.Schematic representation of mesenchymal stem cells (MSCs) differentiation from bone marrow.
Friedenstein et al. first discovered MSCs in bone marrow 1. Decades of studies have offered significant in-depth understanding of these cells and have been reported from, but not limited to, bone marrow 2. Additionally, cells that exhibit characteristics of MSCs have been isolated from adipose tissue 3,4, amniotic fluid 5,6, dental tissues 7, endometrium 8, menstrual blood 9, peripheral blood 10, placenta and fetal membrane 11. Mesenchymal stem cells can be defined by the combination of different surface markers protein like NT5E/CD73, THY1/ CD90 and, ENG/CD105 (Figure 2).
Figure 2.Immunohistochemical staining of Endoglin/CD105 in the human blood vessels using Anti-ENG monoclonal antibody (AMAb90925).
Fibroblasts and Connective Tissue Cells
Fibroblasts or connective tissue cells (also known as stromal cells) provide support and structure for the different organs. Among other things, they also play an essential role in the production, maintenance and remodeling of the extracellular matrix. Figure 3 shows immunostaining for the fibroblast’s marker HSP47/SerpinH1 in the human esophagus.
Chondrocytes and Cartilage Cells
Chondrocytes are primarily mesodermal in origin and are the sole cellular constituents of normal cartilaginous tissue. Chondrocytes are responsible for the synthesis of the two major constituents of the matrix (collagens and proteoglycans) and enzymes that degrade matrix components. Hence, the chondrocyte plays a key role in the regulation of cartilage synthesis and degradation. Differentiation of MSCs into chondrocytes is regulated by transcription factors, like SOX9.
Adipocytes and White Fat Tissue Cells
Adipocytes are highly specialized cells that play an essential role in the energy expenditure of most vertebrates. Adipocytes convert excess energy to fat and deposit it during feeding in preparation for periods of food deprivation. They have a distinct “signet-ring” morphology containing one or more large triglyceride (fat) droplets, which distinguish them from the lipid-deficient stromal/vascular cells. Figure 4 shows immunohistochemical staining for PLN1 (perilipin 1) which is a marker for adipocytes.
Osteoblasts and Bone Cells
Osteoblasts are the cells responsible for bone tissue formation and remodeling. The bone formation (osteogenesis) either occurs from a cartilage precursor or from a layer of osteoblasts on the bone surface, like in the long bones of the skeleton. The main function of osteoblasts is to synthesize collagen type I and other specialized matrix proteins that serve as a template for the subsequent calcium deposition. Osteoblasts differentiation is regulated for example by the master gene regulatory factor OX/SP7.
Smooth, Cardiac, and Skeletal Muscle Cells
A myocyte is the functional cell type of muscle tissue. There are three different types of myocytes with distinct properties and include smooth, cardiac and skeletal muscle cells. Smooth muscle cells (SMC) build up as involuntarily controlled, non-striated muscles in the walls of visceral tissues and blood vessels. The master regulation of smooth muscle gene expression is mediated by myocardin. Cardiomyocytes, or heart muscle cells, are involuntarily controlled, striated cells confined to the heart. Cardiomyocytes are, among other factors, regulated by GATA4 and myocardin. Skeletal muscle cells are striated muscle cells under voluntary control and are attached to the skeleton by tendons. MyoD1 is a key regulator of skeletal (striatal) muscle cell differentiation. Figures 5A-C show immunostainings exemplifying specific antibody markers for each type of muscle cell.

Figure 5A.Immunohistochemical staining of smooth muscle cell (SMC) showing high expression of Transgelin using Anti-TAGLN polyclonal antibody (HPA019467).

Figure 5B.Immunohistochemical staining of cardiac muscle cell showing high expression of Fatty Acid Binding Protein 3 in human heart muscle using Anti-FABP3 polyclonal antibody (HPA055754).

Figure 5C.Immunohistochemical staining of skeletal muscle cell (SMC) showing high expression of Troponin t type 1 using Anti-TNNT1 polyclonal Antibody (HPA058448).
Available Mesenchymal Stem Cell Markers and Antibodies
* Products with enhanced validation for indicated application
References
For Research Use Only. Not for use in diagnostic procedures.
Unless otherwise stated in the Product(s) specifications, any Antibody product is sold for internal research use only and may not be used for any other purpose, which includes but is not limited to, any commercial, diagnostic, or therapeutic use. Our validation processes pertain only to research uses and do not confirm or assure that our antibodies can be used for any unauthorized uses as set forth herein.
To continue reading please sign in or create an account.
Don't Have An Account?
